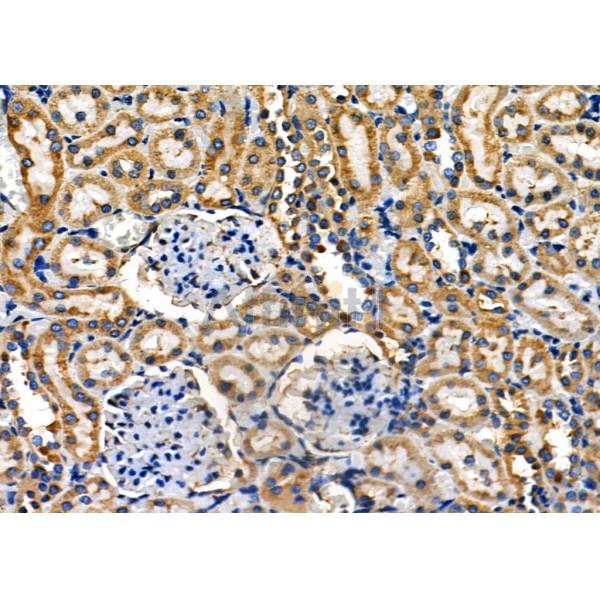
PUM1 Antibody - DF7902 at 1/100 staining Rat kidney tissue by IHC-P.

PUM1 Antibody - #DF7902
| Product: | PUM1 Antibody |
| Catalog: | DF7902 |
| Description: | Rabbit polyclonal antibody to PUM1 |
| Application: | WB IHC |
| Reactivity: | Human, Mouse |
| Prediction: | Pig, Bovine, Horse, Sheep, Rabbit, Dog |
| Mol.Wt.: | 126 kDa; 126kD(Calculated). |
| Uniprot: | Q14671 |
| RRID: | AB_2841319 |
Related Downloads
Protocols
Product Info
*The optimal dilutions should be determined by the end user. For optimal experimental results, antibody reuse is not recommended.
*Tips:
WB: For western blot detection of denatured protein samples. IHC: For immunohistochemical detection of paraffin sections (IHC-p) or frozen sections (IHC-f) of tissue samples. IF/ICC: For immunofluorescence detection of cell samples. ELISA(peptide): For ELISA detection of antigenic peptide.
Cite Format: Affinity Biosciences Cat# DF7902, RRID:AB_2841319.
Fold/Unfold
HsPUM; KIAA0099; PUM 1; PUM L1; Pum1; PUM1_HUMAN; PUMH 1; PUMH; PUMH1; pumilio homolog 1 (Drosophila); Pumilio homolog 1; Pumilio-1; Pumilio1; PUML 1; PUML1;
Immunogens
A synthesized peptide derived from human PUM1, corresponding to a region within the internal amino acids.
Expressed in brain, heart, kidney, muscle, intestine and stomach. Not expressed in cerebellum, corpus callosum, caudate nucleus, hippocampus, medulla oblongata and putamen. Expressed in all fetal tissues tested.
- Q14671 PUM1_HUMAN:
- Protein BLAST With
- NCBI/
- ExPASy/
- Uniprot
MSVACVLKRKAVLWQDSFSPHLKHHPQEPANPNMPVVLTSGTGSQAQPQPAANQALAAGTHSSPVPGSIGVAGRSQDDAMVDYFFQRQHGEQLGGGGSGGGGYNNSKHRWPTGDNIHAEHQVRSMDELNHDFQALALEGRAMGEQLLPGKKFWETDESSKDGPKGIFLGDQWRDSAWGTSDHSVSQPIMVQRRPGQSFHVNSEVNSVLSPRSESGGLGVSMVEYVLSSSPGDSCLRKGGFGPRDADSDENDKGEKKNKGTFDGDKLGDLKEEGDVMDKTNGLPVQNGIDADVKDFSRTPGNCQNSANEVDLLGPNQNGSEGLAQLTSTNGAKPVEDFSNMESQSVPLDPMEHVGMEPLQFDYSGTQVPVDSAAATVGLFDYNSQQQLFQRPNALAVQQLTAAQQQQYALAAAHQPHIGLAPAAFVPNPYIISAAPPGTDPYTAGLAAAATLGPAVVPHQYYGVTPWGVYPASLFQQQAAAAAAATNSANQQTTPQAQQGQQQVLRGGASQRPLTPNQNQQGQQTDPLVAAAAVNSALAFGQGLAAGMPGYPVLAPAAYYDQTGALVVNAGARNGLGAPVRLVAPAPVIISSSAAQAAVAAAAASANGAAGGLAGTTNGPFRPLGTQQPQPQPQQQPNNNLASSSFYGNNSLNSNSQSSSLFSQGSAQPANTSLGFGSSSSLGATLGSALGGFGTAVANSNTGSGSRRDSLTGSSDLYKRTSSSLTPIGHSFYNGLSFSSSPGPVGMPLPSQGPGHSQTPPPSLSSHGSSSSLNLGGLTNGSGRYISAAPGAEAKYRSASSASSLFSPSSTLFSSSRLRYGMSDVMPSGRSRLLEDFRNNRYPNLQLREIAGHIMEFSQDQHGSRFIQLKLERATPAERQLVFNEILQAAYQLMVDVFGNYVIQKFFEFGSLEQKLALAERIRGHVLSLALQMYGCRVIQKALEFIPSDQQNEMVRELDGHVLKCVKDQNGNHVVQKCIECVQPQSLQFIIDAFKGQVFALSTHPYGCRVIQRILEHCLPDQTLPILEELHQHTEQLVQDQYGNYVIQHVLEHGRPEDKSKIVAEIRGNVLVLSQHKFASNVVEKCVTHASRTERAVLIDEVCTMNDGPHSALYTMMKDQYANYVVQKMIDVAEPGQRKIVMHKIRPHIATLRKYTYGKHILAKLEKYYMKNGVDLGPICGPPNGII
Predictions
Score>80(red) has high confidence and is suggested to be used for WB detection. *The prediction model is mainly based on the alignment of immunogen sequences, the results are for reference only, not as the basis of quality assurance.
High(score>80) Medium(80>score>50) Low(score<50) No confidence
Research Backgrounds
Sequence-specific RNA-binding protein that acts as a post-transcriptional repressor by binding the 3'-UTR of mRNA targets. Binds to an RNA consensus sequence, the Pumilio Response Element (PRE), 5'-UGUANAUA-3', that is related to the Nanos Response Element (NRE). Mediates post-transcriptional repression of transcripts via different mechanisms: acts via direct recruitment of the CCR4-POP2-NOT deadenylase leading to translational inhibition and mRNA degradation. Also mediates deadenylation-independent repression by promoting accessibility of miRNAs. Following growth factor stimulation, phosphorylated and binds to the 3'-UTR of CDKN1B/p27 mRNA, inducing a local conformational change that exposes miRNA-binding sites, promoting association of miR-221 and miR-222, efficient suppression of CDKN1B/p27 expression, and rapid entry to the cell cycle. Acts as a post-transcriptional repressor of E2F3 mRNAs by binding to its 3'-UTR and facilitating miRNA regulation. Represses a program of genes necessary to maintain genomic stability such as key mitotic, DNA repair and DNA replication factors. Its ability to repress those target mRNAs is regulated by the lncRNA NORAD (non-coding RNA activated by DNA damage) which, due to its high abundance and multitude of PUMILIO binding sites, is able to sequester a significant fraction of PUM1 and PUM2 in the cytoplasm. Involved in neuronal functions by regulating ATXN1 mRNA levels: acts by binding to the 3'-UTR of ATXN1 transcripts, leading to their down-regulation independently of the miRNA machinery. Plays a role in cytoplasmic sensing of viral infection. In testis, acts as a post-transcriptional regulator of spermatogenesis by binding to the 3'-UTR of mRNAs coding for regulators of p53/TP53. Involved in embryonic stem cell renewal by facilitating the exit from the ground state: acts by targeting mRNAs coding for naive pluripotency transcription factors and accelerates their down-regulation at the onset of differentiation (By similarity). Binds specifically to miRNA MIR199A precursor, with PUM2, regulates miRNA MIR199A expression at a postranscriptional level.
Phosphorylation at Ser-714 promotes RNA-binding activity. Following growth factor stimulation phosphorylated at Ser-714, promoting binding to the 3'-UTR of CDKN1B/p27 mRNA.
Cytoplasm. Cytoplasm>P-body. Cytoplasmic granule.
Note: Recruited to cytoplasmic stress granules upon viral infection.
Expressed in brain, heart, kidney, muscle, intestine and stomach. Not expressed in cerebellum, corpus callosum, caudate nucleus, hippocampus, medulla oblongata and putamen. Expressed in all fetal tissues tested.
The pumilio repeats mediate the association with RNA by packing together to form a right-handed superhelix that approximates a half donut. RNA-binding occurs on the concave side of the surface (PubMed:21397187). PUM1 is composed of 8 pumilio repeats of 36 residues; each repeat binds a single nucleotide in its RNA target. Residues at positions 12 and 16 of the pumilio repeat bind each RNA base via hydrogen bonding or van der Waals contacts with the Watson-Crick edge, while the amino acid at position 13 makes a stacking interaction. The recognition of RNA by pumilio repeats is base specific: cysteine and glutamine at position 12 and 16, respectively, bind adenine; asparagine and glutamine bind uracil; and serine and glutamate bind guanine (PubMed:21572425. PubMed:18328718, PubMed:21653694).
Restrictive clause
Affinity Biosciences tests all products strictly. Citations are provided as a resource for additional applications that have not been validated by Affinity Biosciences. Please choose the appropriate format for each application and consult Materials and Methods sections for additional details about the use of any product in these publications.
For Research Use Only.
Not for use in diagnostic or therapeutic procedures. Not for resale. Not for distribution without written consent. Affinity Biosciences will not be held responsible for patent infringement or other violations that may occur with the use of our products. Affinity Biosciences, Affinity Biosciences Logo and all other trademarks are the property of Affinity Biosciences LTD.